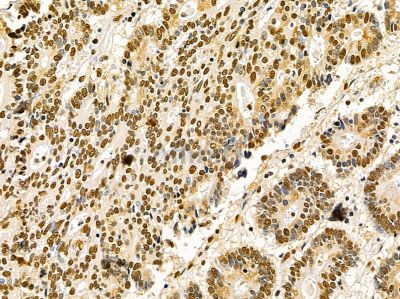
Ku70/80 Mouse Monoclonal Antibody - BF8506 at 1/100 staining human colorectal cancer by IHC-P.

AFfirm™ Ku70/80 Mouse Monoclonal Antibody - #BF8506
Product Info
*The optimal dilutions should be determined by the end user. For optimal experimental results, antibody reuse is not recommended.
*Tips:
WB: For western blot detection of denatured protein samples. IHC: For immunohistochemical detection of paraffin sections (IHC-p) or frozen sections (IHC-f) of tissue samples. IF/ICC: For immunofluorescence detection of cell samples. ELISA(peptide): For ELISA detection of antigenic peptide.
Fold/Unfold
5''-deoxyribose-5-phosphate lyase Ku70; 5''-dRP lyase Ku70; 70 kDa subunit of Ku antigen; ATP dependent DNA helicase 2 subunit 1; ATP dependent DNA helicase II 70 kDa subunit; ATP-dependent DNA helicase 2 subunit 1; ATP-dependent DNA helicase II 70 kDa subunit; CTC box binding factor 75 kDa subunit; CTC box-binding factor 75 kDa subunit; CTC75; CTCBF; DNA repair protein XRCC6; G22P1; Ku 70; Ku autoantigen p70 subunit; Ku autoantigen, 70kDa; Ku p70; Ku70; Ku70 DNA binding component of DNA-dependent proteinkinase complex (thyroid autoantigen 70 kDa; Kup70; Lupus Ku autoantigen protein p70; ML8; Thyroid autoantigen 70kD (Ku antigen); Thyroid autoantigen; Thyroid lupus autoantigen; Thyroid lupus autoantigen p70; Thyroid-lupus autoantigen; TLAA; X ray repair complementing defective repair in Chinese hamster cells 6; X-ray repair complementing defective repair in Chinese hamster cells 6; X-ray repair cross-complementing protein 6; XRCC 6; Xrcc6; XRCC6_HUMAN; 86 kDa subunit of Ku antigen; ATP dependent DNA helicase 2 subunit 2; ATP dependent DNA helicase II 80 kDa subunit; ATP dependent DNA helicase II 86 Kd subunit; ATP dependent DNA helicase II; ATP-dependent DNA helicase 2 subunit 2; ATP-dependent DNA helicase II 80 kDa subunit; CTC box binding factor 85 kDa; CTC box-binding factor 85 kDa subunit; CTC85; CTCBF; DNA repair protein XRCC5; KARP 1; KARP1; Ku 80; Ku autoantigen 80kDa; Ku80; Ku86; Ku86 autoantigen related protein 1; KUB 2; KUB2; Lupus Ku autoantigen protein p86; NFIV; Nuclear factor IV; Thyroid lupus autoantigen; Thyroid-lupus autoantigen; TLAA; X ray repair complementing defective repair in Chinese hamster cells 5 (double strand break rejoining); X-ray repair complementing defective repair in Chinese hamster cells 5 (double-strand-break rejoining); X-ray repair cross-complementing protein 5; Xray repair complementing defective repair in Chinese hamster cells 5; XRCC 5; XRCC5; XRCC5_HUMAN;
Immunogens
A synthesized peptide derived from human Ku70/80, corresponding to a region within the internal amino acids.
- P12956 XRCC6_HUMAN:
- Protein BLAST With
- NCBI/
- ExPASy/
- Uniprot
MSGWESYYKTEGDEEAEEEQEENLEASGDYKYSGRDSLIFLVDASKAMFESQSEDELTPFDMSIQCIQSVYISKIISSDRDLLAVVFYGTEKDKNSVNFKNIYVLQELDNPGAKRILELDQFKGQQGQKRFQDMMGHGSDYSLSEVLWVCANLFSDVQFKMSHKRIMLFTNEDNPHGNDSAKASRARTKAGDLRDTGIFLDLMHLKKPGGFDISLFYRDIISIAEDEDLRVHFEESSKLEDLLRKVRAKETRKRALSRLKLKLNKDIVISVGIYNLVQKALKPPPIKLYRETNEPVKTKTRTFNTSTGGLLLPSDTKRSQIYGSRQIILEKEETEELKRFDDPGLMLMGFKPLVLLKKHHYLRPSLFVYPEESLVIGSSTLFSALLIKCLEKEVAALCRYTPRRNIPPYFVALVPQEEELDDQKIQVTPPGFQLVFLPFADDKRKMPFTEKIMATPEQVGKMKAIVEKLRFTYRSDSFENPVLQQHFRNLEALALDLMEPEQAVDLTLPKVEAMNKRLGSLVDEFKELVYPPDYNPEGKVTKRKHDNEGSGSKRPKVEYSEEELKTHISKGTLGKFTVPMLKEACRAYGLKSGLKKQELLEALTKHFQD
- P13010 XRCC5_HUMAN:
- Protein BLAST With
- NCBI/
- ExPASy/
- Uniprot
MVRSGNKAAVVLCMDVGFTMSNSIPGIESPFEQAKKVITMFVQRQVFAENKDEIALVLFGTDGTDNPLSGGDQYQNITVHRHLMLPDFDLLEDIESKIQPGSQQADFLDALIVSMDVIQHETIGKKFEKRHIEIFTDLSSRFSKSQLDIIIHSLKKCDISLQFFLPFSLGKEDGSGDRGDGPFRLGGHGPSFPLKGITEQQKEGLEIVKMVMISLEGEDGLDEIYSFSESLRKLCVFKKIERHSIHWPCRLTIGSNLSIRIAAYKSILQERVKKTWTVVDAKTLKKEDIQKETVYCLNDDDETEVLKEDIIQGFRYGSDIVPFSKVDEEQMKYKSEGKCFSVLGFCKSSQVQRRFFMGNQVLKVFAARDDEAAAVALSSLIHALDDLDMVAIVRYAYDKRANPQVGVAFPHIKHNYECLVYVQLPFMEDLRQYMFSSLKNSKKYAPTEAQLNAVDALIDSMSLAKKDEKTDTLEDLFPTTKIPNPRFQRLFQCLLHRALHPREPLPPIQQHIWNMLNPPAEVTTKSQIPLSKIKTLFPLIEAKKKDQVTAQEIFQDNHEDGPTAKKLKTEQGGAHFSVSSLAEGSVTSVGSVNPAENFRVLVKQKKASFEEASNQLINHIEQFLDTNETPYFMKSIDCIRAFREEAIKFSEEQRFNNFLKALQEKVEIKQLNHFWEIVVQDGITLITKEEASGSSVTAEEAKKFLAPKDKPSGDTAAVFEEGGDVDDLLDMI
Research Backgrounds
Single-stranded DNA-dependent ATP-dependent helicase. Has a role in chromosome translocation. The DNA helicase II complex binds preferentially to fork-like ends of double-stranded DNA in a cell cycle-dependent manner. It works in the 3'-5' direction. Binding to DNA may be mediated by XRCC6. Involved in DNA non-homologous end joining (NHEJ) required for double-strand break repair and V(D)J recombination. The XRCC5/6 dimer acts as regulatory subunit of the DNA-dependent protein kinase complex DNA-PK by increasing the affinity of the catalytic subunit PRKDC to DNA by 100-fold. The XRCC5/6 dimer is probably involved in stabilizing broken DNA ends and bringing them together. The assembly of the DNA-PK complex to DNA ends is required for the NHEJ ligation step. Required for osteocalcin gene expression. Probably also acts as a 5'-deoxyribose-5-phosphate lyase (5'-dRP lyase), by catalyzing the beta-elimination of the 5' deoxyribose-5-phosphate at an abasic site near double-strand breaks. 5'-dRP lyase activity allows to 'clean' the termini of abasic sites, a class of nucleotide damage commonly associated with strand breaks, before such broken ends can be joined. The XRCC5/6 dimer together with APEX1 acts as a negative regulator of transcription. Plays a role in the regulation of DNA virus-mediated innate immune response by assembling into the HDP-RNP complex, a complex that serves as a platform for IRF3 phosphorylation and subsequent innate immune response activation through the cGAS-STING pathway.
Phosphorylation by PRKDC may enhance helicase activity. Phosphorylation of Ser-51 does not affect DNA repair.
ADP-ribosylated by PARP3.
Nucleus. Chromosome.
Belongs to the ku70 family.
Single-stranded DNA-dependent ATP-dependent helicase. Has a role in chromosome translocation. The DNA helicase II complex binds preferentially to fork-like ends of double-stranded DNA in a cell cycle-dependent manner. It works in the 3'-5' direction. Binding to DNA may be mediated by XRCC6. Involved in DNA non-homologous end joining (NHEJ) required for double-strand break repair and V(D)J recombination. The XRCC5/6 dimer acts as regulatory subunit of the DNA-dependent protein kinase complex DNA-PK by increasing the affinity of the catalytic subunit PRKDC to DNA by 100-fold. The XRCC5/6 dimer is probably involved in stabilizing broken DNA ends and bringing them together. The assembly of the DNA-PK complex to DNA ends is required for the NHEJ ligation step. In association with NAA15, the XRCC5/6 dimer binds to the osteocalcin promoter and activates osteocalcin expression. The XRCC5/6 dimer probably also acts as a 5'-deoxyribose-5-phosphate lyase (5'-dRP lyase), by catalyzing the beta-elimination of the 5' deoxyribose-5-phosphate at an abasic site near double-strand breaks. XRCC5 probably acts as the catalytic subunit of 5'-dRP activity, and allows to 'clean' the termini of abasic sites, a class of nucleotide damage commonly associated with strand breaks, before such broken ends can be joined. The XRCC5/6 dimer together with APEX1 acts as a negative regulator of transcription. Plays a role in the regulation of DNA virus-mediated innate immune response by assembling into the HDP-RNP complex, a complex that serves as a platform for IRF3 phosphorylation and subsequent innate immune response activation through the cGAS-STING pathway.
ADP-ribosylated by PARP3.
Phosphorylated on serine residues. Phosphorylation by PRKDC may enhance helicase activity.
Sumoylated.
Ubiquitinated by RNF8 via 'Lys-48'-linked ubiquitination following DNA damage, leading to its degradation and removal from DNA damage sites. Ubiquitinated by RNF138, leading to remove the Ku complex from DNA breaks.
Nucleus. Nucleus>Nucleolus. Chromosome.
The EEXXXDDL motif is required for the interaction with catalytic subunit PRKDC and its recruitment to sites of DNA damage.
Belongs to the ku80 family.
Research Fields
· Genetic Information Processing > Replication and repair > Non-homologous end-joining.
Restrictive clause
Affinity Biosciences tests all products strictly. Citations are provided as a resource for additional applications that have not been validated by Affinity Biosciences. Please choose the appropriate format for each application and consult Materials and Methods sections for additional details about the use of any product in these publications.
For Research Use Only.
Not for use in diagnostic or therapeutic procedures. Not for resale. Not for distribution without written consent. Affinity Biosciences will not be held responsible for patent infringement or other violations that may occur with the use of our products. Affinity Biosciences, Affinity Biosciences Logo and all other trademarks are the property of Affinity Biosciences LTD.